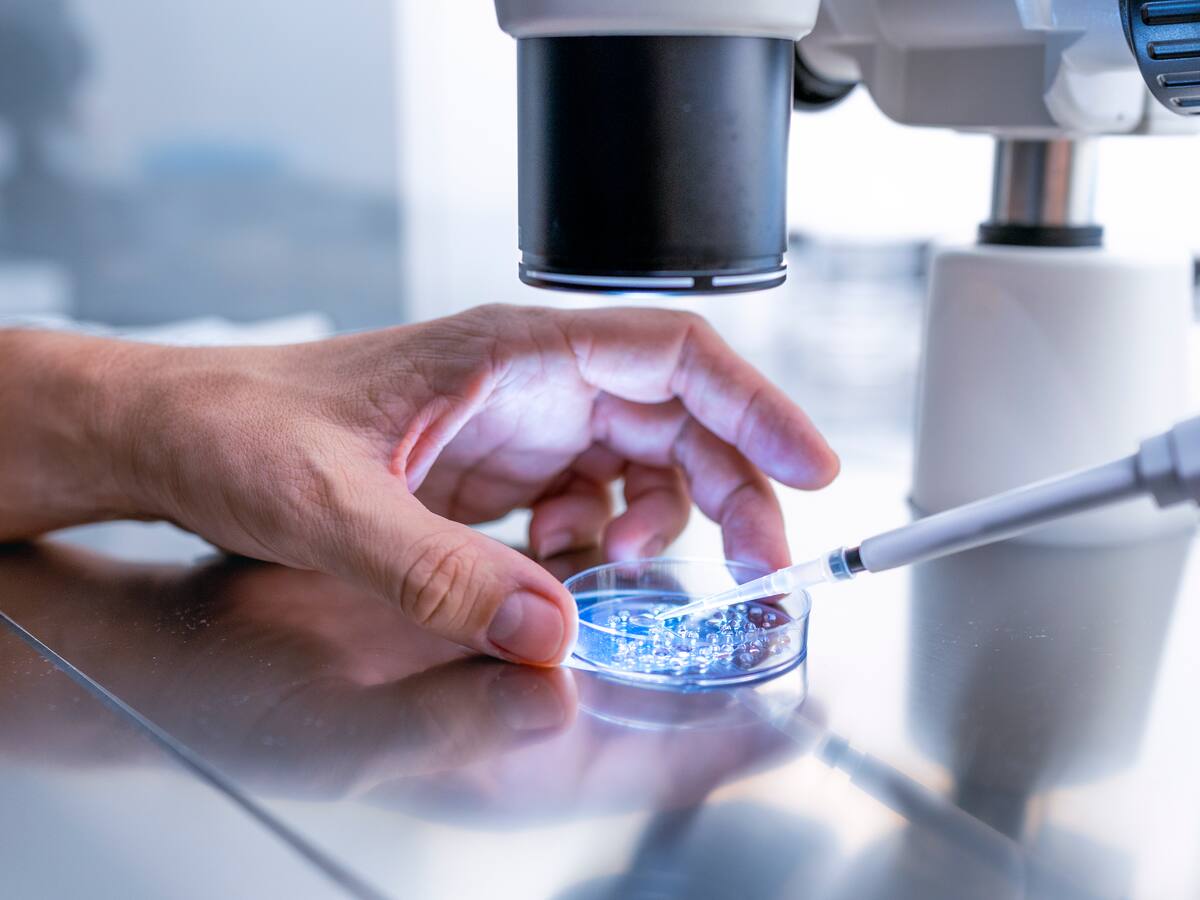
La Rioja estudia ampliar de 40 a 42 años la edad máxima para tratamientos de fertilidad

Escuchar
01:29
Logroño pone a la venta 10 parcelas para construir 136 viviendas de protección oficial
La licitación de estos solares se realiza por un importe total de 4,34 millones de euros
08/01/2025 - 18:54
Redacción | EP
Logroño
Selecciona tu emisora
El código iframe se ha copiado en el portapapeles
17/02/2026 04:48
Escuchar
01:29
La licitación de estos solares se realiza por un importe total de 4,34 millones de euros
08/01/2025 - 18:54
Redacción | EP
Logroño

08/01/2025 - 16:15
Redacción
Logroño

08/01/2025 - 15:11
Redacción
Logroño
08/01/2025 - 14:32
Redacción
La Rioja

08/01/2025 - 09:09
Beatriz Jordán
Logroño

07/01/2025 - 19:35
Redacción | EP

07/01/2025 - 14:04
Redacción
Logroño
07/01/2025 - 13:18
Redacción
Logroño

07/01/2025 - 12:32
Redacción
Logroño

07/01/2025 - 10:48
Redacción

07/01/2025 - 08:56
Beatriz Jordán
Logroño

06/01/2025 - 14:35
Beatriz Jordán
Logroño

06/01/2025 - 14:18
Redacción
La Rioja

06/01/2025 - 13:14
Redacción | EFE
Logroño

05/01/2025 - 21:34
Redacción
Logroño

05/01/2025 - 21:08
Redacción
Logroño

05/01/2025 - 15:02
Redacción
Logroño

05/01/2025 - 12:18
Redacción
Logroño

05/01/2025 - 01:34
EFE
Logroño

04/01/2025 - 14:32
Beatriz Jordán
Logroño

04/01/2025 - 10:26
Redacción
Logroño

04/01/2025 - 10:24
Redacción
Logroño

03/01/2025 - 13:03
EFE | Redacción
Logroño

03/01/2025 - 12:26
EP
Logroño
03/01/2025 - 10:46
Redacción
Logroño

03/01/2025 - 08:47
Beatriz Jordán
Logroño

02/01/2025 - 14:48
Redacción
Logroño

02/01/2025 - 13:38
Redacción
Logroño

02/01/2025 - 13:14
Redacción
Logroño

02/01/2025 - 09:09
Beatriz Jordán
Logroño

01/01/2025 - 13:46
Víctor Espuelas
Logroño

01/01/2025 - 11:09
Redacción
Logroño

01/01/2025 - 10:47
Redacción
Logroño

01/01/2025 - 10:30
Redacción
Logroño

01/01/2025 - 08:43
Redacción
Logroño

31/12/2024 - 14:04
Redacción
Logroño

31/12/2024 - 13:47
Redacción
Logroño

31/12/2024 - 10:52
Redacción
Logroño

31/12/2024 - 09:34
Redacción
Logroño

31/12/2024 - 09:01
Beatriz Jordán
Logroño
Ahora en directo
Cadena SER
00:00 - 23:59
00:00 - 23:59
Otros directosCadena SER
00:00 - 23:59
Podcast
Síguenos en
Otros episodios
Cualquier tiempo pasado fue anterior
Tu audio se ha acabado.
Te redirigiremos al directo.
5 "